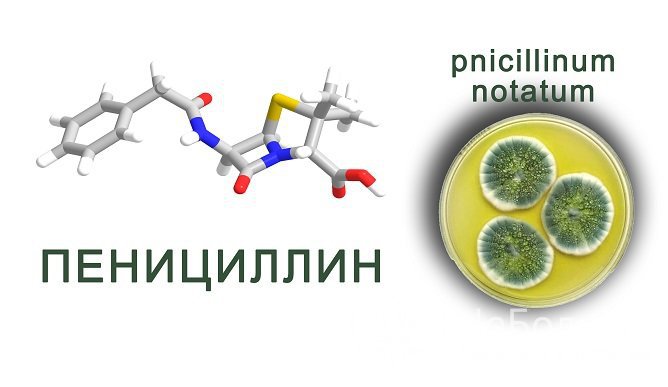
Пенициллины проявляют активность в отношении большинства грамположительных, а также некоторых грамотрицательных микроорганизмов

Воспользуйтесь поиском по сайту:
Антибиотики при гайморите: лечение у взрослых и детей
Содержание статьи:
Гайморит является одним из видов синусита – воспаления околоносовых пазух, которое чаще всего развивается вследствие попадания в них инфекции.
В зависимости от зоны поражения, различают:
- гайморит (другое название – максиллит, верхнечелюстной синусит): воспаление развивается в гайморовых пазухах;
- фронтит: самая тяжелая форма патологии, воспалительный процесс протекает в лобной пазухе;
- этмоидит: инфекция развивается в полостях решетчатой кости;
- сфеноидит: воспаление клиновидной пазухи, обычно протекает в сочетании с этмоидитом и является самой трудно диагностируемой формой заболевания.
 Для диагностики заболевания и назначения адекватного лечения нужно обратиться к отоларингологу
Для диагностики заболевания и назначения адекватного лечения нужно обратиться к отоларингологуПри отсутствии своевременного лечения синуситов, возможны различные осложнения, включая менингит, отит, аденоидит, тонзиллит, бронхит, нефропатию и другие.
Основными причинами развития болезни являются бактериальные и вирусные инфекции, которые попадают в гайморову пазуху через кровь или полость носа, посредством патологических процессов, протекающих в периапикальных областях верхних зубов. Также гайморит может быть осложнением гриппа или ОРВИ (острой респираторной вирусной инфекции).
 Гайморит характеризуется типичными симптомами – головной болью, обильными выделениями из носа, повышением температуры тела
Гайморит характеризуется типичными симптомами – головной болью, обильными выделениями из носа, повышением температуры телаОбщими симптомами верхнечелюстного синусита являются: обильные выделения из носа, болезненные ощущения в области глазниц и лба, повышенная чувствительность лица, увеличение температуры тела и головная боль. Воспаление провоцирует нарушение оттока секрета, выделяемого слизистой оболочкой гайморовой пазухи. Это, в свою очередь, приводит к развитию патологии. Слизь под воздействием патогенных микробов превращается в гной. При отсутствии своевременного лечения гайморит переходит в хроническую форму.
На начальных этапах лечения назначают ингаляции, промывания и закапывания носовой полости. Чтобы правильно проводить эти процедуры в домашних условиях, лучше проконсультироваться с врачом, ознакомиться с тематическими фото или видео. Если на протяжении 7–10 дней гайморит не прошел, применяют антибактериальные препараты, которые позволяют избавиться от инфекции и очистить гайморовы пазухи от накопившегося гноя.
Как подобрать наиболее эффективный антибиотик от гайморита
Антибактериальную терапию должен назначать отоларинголог (ЛОР), поскольку он сможет определить, нужно ли ее проводить, и подберет наиболее действенный препарат. С этой целью врач собирает информацию об истории заболевания, учитывает результаты анализов, возраст пациента, наличие аллергий, принимает во внимание сведения о ранее принимаемых антибактериальных средствах.
 Не следует применять антибиотики без назначения врача
Не следует применять антибиотики без назначения врачаНа основании полученных данных ЛОР назначает больному антибиотик, к которому нет противопоказаний или аллергии, а возбудитель заболевания проявляет наибольшую чувствительность. Большинство антибиотиков нового поколения обладают широким спектром действия и активны в отношении практически всех бактерий, вызывающих ЛОР-болезни. В связи с этим необходимость в проведении бактериального посева для установления конкретного возбудителя заболевания возникает только в тех случаях, когда отсутствует эффект при проводимом медикаментозном лечении.
Пенициллиновые препараты относятся к наиболее безопасным для лечения максиллита антибиотикам, однако, в виду их многолетнего применения, у многих бактерий выработалась к ним устойчивость.
Антибиотики выпускаются в разных лекарственных формах, включая таблетки, растворы для промывания носа, спреи, капли, растворы для инъекций. Самостоятельный выбор препарата не рекомендуется, поскольку он может оказаться неэффективным и даже усугубить состояние больного.
Противопоказания для антибиотикотерапии при гайморите
Большинство антибактериальных средств широкого спектра действия противопоказаны или с особой осторожностью применяются в следующих случаях:
- патологии почек и/или печени;
- сердечно-сосудистые заболевания;
- аллергический, грибковый или вирусный гайморит;
- детский возраст младше 12 лет;
- беременность;
- период грудного вскармливания;
- повышенная чувствительность к компонентам, входящим в состав антибиотика.
Подробный перечень абсолютных и относительных противопоказаний указывается в инструкции к препарату.
Возможные побочные эффекты при лечении антибиотиками
При правильном подборе антибактериального средства улучшение состояния пациента наблюдается в короткие сроки. Однако, даже при применении подходящего препарата, возможно развитие таких побочных эффектов, как:
- отечность горла или лица;
- затруднение дыхания;
- сыпь, покраснение и иные кожные проявления;
- обморок;
- усиленное головокружение;
- расстройства со стороны желудочно-кишечного тракта.
Важно при появлении побочных реакций своевременно обратиться к врачу. Самостоятельный подбор препаратов в таких случаях, без учета возможного их взаимодействия с принимаемым антибиотиком, может послужить развитию серьезных осложнений.
Подробный перечень вероятных побочных действий указан в инструкции к применению препарата.
Группы антибактериальных препаратов
Антибиотиками называют вещества синтетического, полусинтетического или природного происхождения, подавляющие рост живых клеток.
По характеру воздействия на бактериальную клетку их разделяют на две группы:
- бактерицидные: при их приеме бактерии погибают и выводятся из организма;
- бактериостатические: бактерии после применения таких средств остаются живы, но их размножение становится невозможным.
По химической структуре выделяют следующие антибактериальные средства:
- β-лактамные: группа антибиотиков, которые содержат в структуре β-лактамное кольцо. Они подразделяются на пенициллины, цефалоспорины, карбапенемы и монобактамы. Пенициллины вырабатывают колонии плесневого грибка Penicillium. Цефалоспорины схожи с ними по структуре и применяются в отношении пенициллин устойчивых бактерий. Структура карбапенемов более устойчива к β-лактамазам, нежели у пенициллинов и цефалоспоринов, за счет чего они обладают более широким спектром действия;
- макролиды: оказывают бактериостатическое действие, обладают сложной циклической структурой;
- тетрациклины: антибиотики бактериостатического действия, применяемые для терапии инфекций мочевыводящих и дыхательных путей, тяжелых инфекций типа бруцеллеза, туляремии и сибирской язвы;
- аминогликозиды: оказывают бактерицидное действие, обладают высокой токсичностью. Их используют при тяжелых инфекциях (заражения крови, перитониты);
- левомицетины: оказывают бактериостатическое действие, их применение ограничено, поскольку на фоне их приема возможно поражение костного мозга, вырабатывающего клетки крови;
- гликопептиды: нарушают синтез клеточной стенки бактерий, обладают бактерицидным действием, но по отношению к энтерококкам, некоторым стрептококкам и стафилококкам действуют бактериостатически;
- линкозамиды: посредством ингибирования синтеза белка рибосомами оказывают бактериостатическое действие. При их приеме в высоких концентрациях может проявляться бактерицидный эффект в отношении высокочувствительных микроорганизмов;
- противотуберкулезные средства: антибиотики, активные в отношении палочки Коха;
- антибиотики разных групп (Гелиомицин, Фузидин-натрий, Рифамицин и другие);
- противогрибковые антибиотики: оказывают литическое действие, разрушают мембрану клеток грибков и вызывают их гибель;
- противолепрозные средства (Диуцифон, Солюсульфон, Диафенилсульфон).
Цефалоспорины назначают только при тяжелом течении гайморита, когда применение других антибиотиков оказалось неэффективным.
Для лечения гайморита антибиотиками у взрослых и детей применяются макролиды, пенициллины, фторхинолоны и цефалоспорины.
Читайте также:
Антибиотики при гайморите
Антибактериальное лечение назначается при остром течении максиллита и развитии серьезных осложнений на фоне хронической формы воспаления. Оно может проводиться в домашних условиях либо, при тяжелом течении заболевания, в стационаре. В большинстве случаев медикаментозная терапия дает положительные результаты, и пациент быстро идет на поправку. Если в течение трех дней приема лекарства не наблюдается улучшение, рекомендуется обратиться за консультацией к врачу. Он решит, как лечить заболевание дальше, и какие антибиотики будут эффективными в таком случае.
 Антибиотики назначаются только при остром течении гайморита
Антибиотики назначаются только при остром течении гайморитаВажно начатый курс приема антибиотиков доводить до конца, даже если нет температуры и других симптомов гайморита, а общее состояние улучшилось. Это связано с тем, что рецидивы заболевания значительно тяжелее поддаются лечению.
Если больному назначены местные антибиотики (капли, спреи), в обязательном порядке перед их использованием нужно прочистить носовые пазухи. Чтобы предотвратить усиление воспаления, важно следить за тем, чтобы гной отходил из воспаленных полостей. Предварительно до использования любых антибиотиков следует проверить состояние желудочно-кишечного тракта и почек, во избежание обострения имеющихся хронических патологий или развития опасных осложнений.
 Перед введением антибиотиков в виде капель или спрея необходимо прочистить носовые пазухи
Перед введением антибиотиков в виде капель или спрея необходимо прочистить носовые пазухиСпособ применения, дозы, а также, сколько дней принимать лекарственное средство, устанавливает отоларинголог в индивидуальном порядке.
Пенициллиновые антибиотики
- Хиконцил: выпускают в форме порошка, капсул и капель для перорального приема. Непосредственно перед приемом порошок и капли разводят в воде. Продолжительность курса варьирует в пределах от 5 до 12 суток;
- Амосин: препарат в форме порошка для приготовления суспензии для приема внутрь. Его доза напрямую зависит от степени тяжести патологии. Обычно терапию начинают с минимальных доз, а между приемами готовой суспензии в течение дня соблюдают одинаковые промежутки времени. Пить средство рекомендуется не более 12 суток;
- Амоксикар: является антибиотиком последнего поколения, который оказывает быстрое терапевтическое действие при применении даже в небольших дозах. Курс приема лекарства – до 14 суток.
Пенициллины проявляют активность в отношении большинства грамположительных, а также некоторых грамотрицательных микроорганизмов
Пенициллины проявляют активность в отношении большинства грамположительных, а также некоторых грамотрицательных микроорганизмовПенициллиновые препараты относятся к наиболее безопасным для лечения максиллита антибиотикам, однако, в виду их многолетнего применения, у многих бактерий выработалась к ним устойчивость.
Макролиды
- Кларитромицин: выпускают в виде капсул и таблеток, которые принимаются перорально. Активное вещество – кларитромицин, быстро останавливает негативное воздействие болезнетворных бактерий, однако при этом часто вызывает побочные эффекты со стороны печени и желудка. При легком течении воспаления его принимают на протяжении 7 суток (не более), в тяжелых случаях продолжительность курса может быть увеличена до 14 суток;
- Кларбакт: современный антибиотик индийского производства. Выпускается в форме таблеток, покрытых оболочкой, которые необходимо принимать внутрь через 1 час после еды в утреннее и вечернее время. Дозу препарата определяют в зависимости от тяжести состояния. Состав Кларбакта такой же, как и у Кларитромицина, однако он чаще приводит к развитию побочных эффектов. Курс лечения не должен превышать 14 суток, в некоторых случаях может быть достаточно приема в течение 6 суток;
- Экозитрин: более сильный антибиотик макролидической группы, выпускаемый в таблетках. Его прием при легком течении заболевания варьирует в пределах от 7 до 14 суток, при острой форме – 14 суток.
 Макролиды часто являются антибиотиком выбора при терапии гайморита
Макролиды часто являются антибиотиком выбора при терапии гайморитаДанные антибиотики в таблетках при гайморите у взрослых рекомендуется применять при непереносимости пенициллиновой группы или неэффективности ранее проводимой антибактериальной терапии.
Фторхинолоны
- Офлоксацин: современное лекарственное средство, подавляющее многие виды бактерий. Пациентами переносится хорошо, не вызывает серьезных побочных эффектов. Выпускается в таблетках, которые рекомендуется принимать по прошествии одного часа после еды. Длительность курса лечения устанавливается врачом;
- Моксифлоксацин: выпускается в форме таблеток для перорального приема и раствора для инфузий, который колют внутривенно. Для пациентов пожилого возраста коррекции в режиме дозирования Моксифлоксацина не требуется. Терапию проводят под строгим врачебным контролем в течение периода, установленного в индивидуальном порядке.
Применение этой современной группы антибактериальных средств для терапии гайморита является наиболее эффективным, поскольку у бактерий еще не выработалась к ним устойчивость. Однако следует учитывать, что в некоторых случаях на фоне их применения могут развиваться выраженные аллергические реакции, что требует немедленной госпитализации больного.
Цефалоспорины
- Цефазолин: антибиотик первого поколения цефалоспоринов. Выпускается в виде порошка для приготовления раствора для инъекций. Его назначают исключительно при наличии интоксикации организма. Дозировку и продолжительность курса лечения устанавливают индивидуально для каждого пациента. Перед введением антибиотик разводят в изотоническом растворе натрия хлорида или стерильной воде для инъекций. Препарат быстро всасывается, его концентрация в крови сохраняется на протяжении 12 часов. Цефазолин прописывают пациентам с осторожностью, поскольку на фоне терапии могут развиваться побочные эффекты со стороны желудочно-кишечного тракта и аллергия;
- Цефтриаксон: антибиотик третьего поколения, выпускаемый в форме порошка для приготовления раствора для внутривенного и внутримышечного введения. Лекарственное средство применяется лишь при наличии признаков сильного поражения организма бактериями, провоцирующими интоксикацию. Дозу Цефтриаксона подбирают исключительно индивидуально. Его использование возможно только в острой фазе заболевания. В стадии ремиссии его применение не рекомендовано. Введение раствора продолжают до полного снятия острых симптомов гайморита.
Важно начатый курс приема антибиотиков доводить до конца, даже если нет температуры и других симптомов гайморита, а общее состояние улучшилось. Это связано с тем, что рецидивы заболевания значительно тяжелее поддаются лечению.
Цефалоспорины назначают только при тяжелом течении гайморита, когда применение других антибиотиков оказалось неэффективным. После купирования острого периода заболевания проводят немедленную их отмену.
Местные антибиотики
- Изофра: выпускается в форме спрея назального, посредством впрыскиваний вводится в каждый носовой ход. Дозировку устанавливают в зависимости от тяжести воспалительного процесса. Между впрыскиваниями рекомендуется соблюдать одинаковый промежуток времени. Непосредственно перед применением спрея носовую полость следует очистить от отделяемого, используя специальные растворы (к примеру, Аквалор). Терапия Изофрой не должна превышать 7 суток;
- Фраминазин: препарат для местного применения при заболеваниях носа, содержащий антибиотик. Выпускается в форме спрея назального. В случаях поражения носовых пазух Фраминазин не применяется. Кратность использования средства зависит от интенсивности воспалительного процесса. Продолжительность курса терапии устанавливает врач, обычно она не превышает 10 суток. При использовании спрея может наблюдаться повышенная сухость носоглотки;
- Полидекса с фенилэфрином: комбинированное лекарственное средство, действующими веществами которого являются антибиотики (неомицин и полимиксин В), синтетический глюкокортикостероид (дексаметазон) и α-адреномиметик (фенилэфрин). Благодаря такому составу, препарат быстро действует, и уже после первого применения состояние больного значительно улучшается. Препарат выпускается в форме спрея назального, впрыскивания рекомендуется проводить через одинаковые промежутки времени. Продолжительность терапии варьирует в пределах от 5 до 10 суток.
Следует учитывать, что при одновременном назначении спреев и сосудосуживающих капель, между их введением важно соблюдать интервал в один час. Если отоларинголог также назначил промывающие растворы, их применение возможно в любое время.
Видео
Предлагаем к просмотру видеоролик по теме статьи.
Об авторе

Нашли ошибку в тексте? Выделите ее и нажмите Ctrl + Enter.
Кроме людей, от простатита страдает всего одно живое существо на планете Земля – собаки. Вот уж действительно наши самые верные друзья.
























